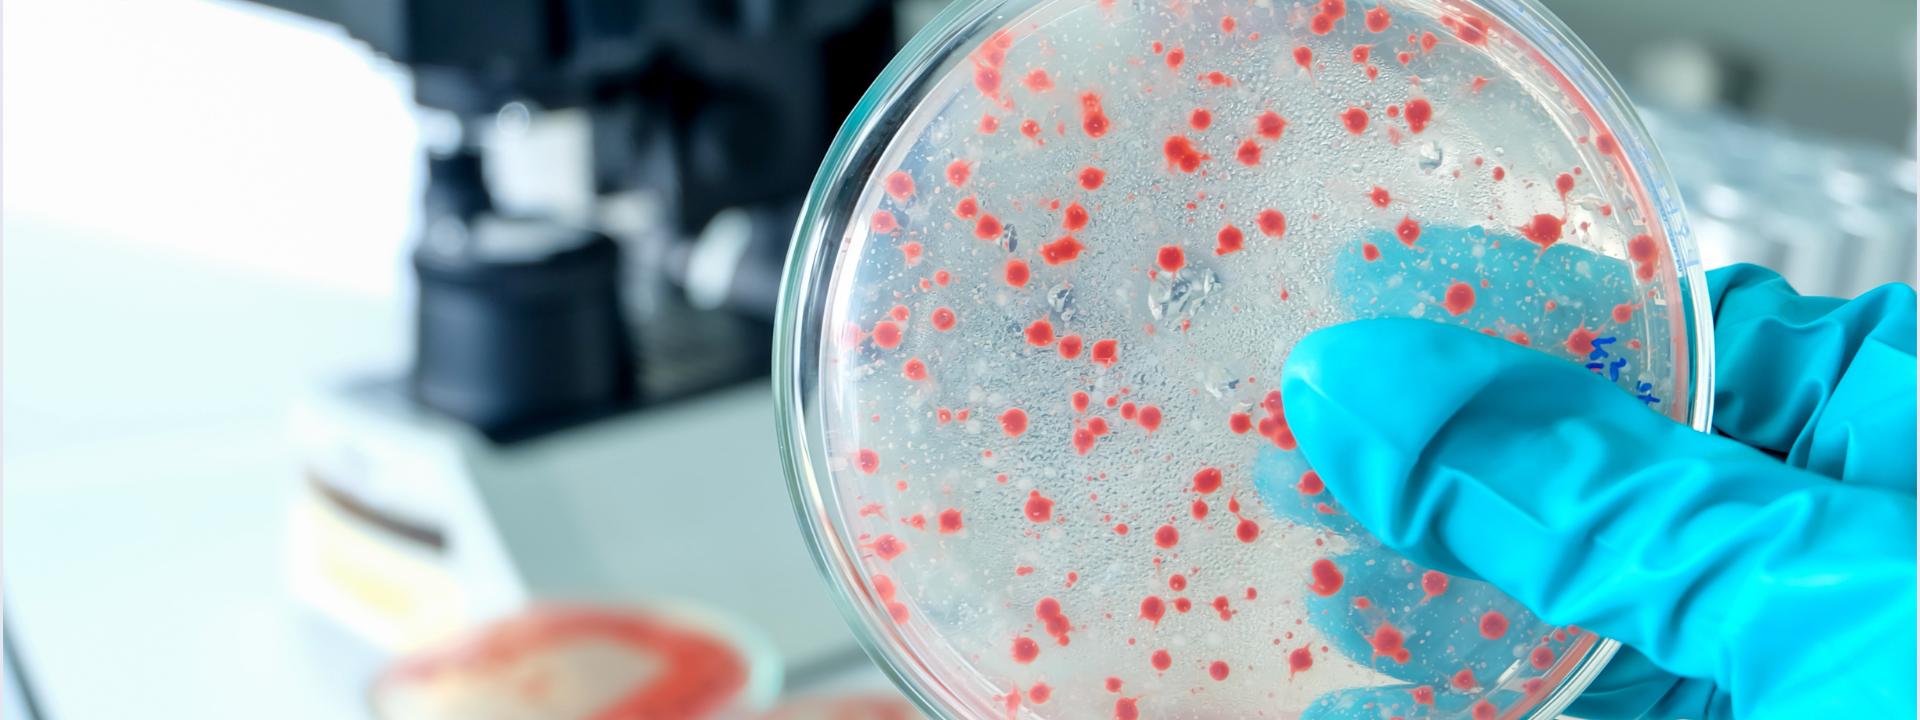

Nos capacités
Protection de vos produits à chaque étape
Tests de qualité microbiologique
Ceci assure la conformité aux réglementations internationales de sécurité ; la détection de la contamination microbienne et la confirmation de l'efficacité du système de conservation sont des étapes vitales.
Dénombrement total viable (Total Viable Count Testing)
Mesure la charge microbienne aérobique, de levures et de moisissures des matières premières et des produits finis afin de surveiller l'hygiène et la qualité microbiologique du produit.
Tests d'efficacité des conservateurs (Challenge Testing)
Vérifie la robustesse du produit en étudiant l'efficacité possible de son système de conservation en présence de contamination microbienne conformément aux dispositions ISO 11930 et EP 5.1.3.
Tests de stérilité
Assurance de la stérilité des cosmétiques contre la contamination microbienne, basée sur des méthodes conformes à l'USP <71>.
Tests d'activité de l'eau (Water Activity Testing)
La mesure de l'aW est secondaire, mais importante pour prédire le potentiel de croissance microbienne et est donc requise pour évaluer la sécurité et la stabilité du produit.
Validation de méthode
La validation couvrira les méthodes de neutralisation, les diluants et les milieux de culture pour toute matrice de produit nécessitant des résultats de test fiables.
Surveillance environnementale
L'hygiène des installations de fabrication permet de surveiller les charges microbiologiques de surface, de l'air et de l'eau afin d'éviter les incidents de contamination croisée.
Identification microbienne
Détermination des sources de contamination via une identification précise au niveau de l'espèce à l'aide de la spectrométrie de masse MALDI-TOF et du séquençage PCR.
Tests de micro-organismes spécifiés
Protège les consommateurs et satisfait aux besoins réglementaires en testant les agents pathogènes tels qu'E. coli, S. aureus et P. aeruginosa par des méthodes ISO et de pharmacopée validées.
Tests microbiologiques personnalisés
Résolution des protocoles personnalisés et assistance à l'investigation pour des exigences spécifiques concernant un produit ou son environnement de production.
Votre casse-tête de conformité – Résolu avec précision
Les fabricants de cosmétiques sont confrontés à une pression réglementaire croissante, notamment en vertu du Règlement UE (CE) 1223/2009. La qualité microbiologique doit être prouvée de la formulation au produit fini – or, beaucoup manquent de ressources pour respecter des normes complexes et en évolution.
C'est là que nous intervenons.
Eurofins propose des services de tests microbiologiques de bout en bout qui garantissent les meilleurs produits de conformité avec des systèmes de conservation efficaces et une possibilité minimale de contamination. Nos laboratoires accrédités se spécialisent dans des résultats rapides et précis, qui sont également dignes de confiance.

Des avantages au-delà de la conformité
Plus que des tests : Eurofins vous apporte confiance et rapidité
En vous connectant à Eurofins, vous accédez à plus qu'un simple fournisseur de tests. Vous accédez à un allié en matière de conformité réglementaire, mettant des compétences techniques inégalées, des connaissances réglementaires et toute l'infrastructure de laboratoire mondiale privée à la disposition de votre processus de contrôle qualité et de développement de produits.
- Laboratoires accrédités : Tous les tests sont effectués par des laboratoires accrédités ISO/CEI 17025 pour les matrices cosmétiques.
- Assistance à la conformité réglementaire : Mise en relation de vos données avec les normes ISO, EP et USP, ainsi que le Règlement CE 1223/2009.
- Plans de tests personnalisés : Solutions adaptées en fonction du type de produit, de la méthode de production et du profil de risque.
- Délais d'exécution réduits : Développez des produits plus rapidement grâce à des flux de travail de tests accélérés et à des rapports rapides.

Votre partenaire de confiance pour les tests de microbiologie
Eurofins fournit des tests microbiologiques accrédités pour les produits cosmétiques. Nous effectuons des tests de contamination microbienne, d'efficacité des conservateurs et de stérilité dans les matières premières, les produits en vrac ou les produits finis conformément aux spécifications ISO, EP et USP.
Notre service comprend le dénombrement total viable, la détection de pathogènes, les tests de provocation, l'analyse de l'activité de l'eau et la surveillance environnementale. De plus, nous soutenons la validation de méthode et l'identification microbienne des résultats à l'aide de MALDI-TOF et PCR. Forts de décennies d'expertise industrielle chez Eurofins, nous aidons à la protection de la qualité des produits et au respect de toutes les exigences et normes mondiales en toute confiance.
Pourquoi nous choisir pour vos besoins en tests de microbiologie ?
Expérience inégalée
Nous servons des marques de soins personnels de premier plan et des fabricants sous contrat en Europe, en Amérique du Nord et en Asie.
Réseau mondial
Accès à plus de 900 laboratoires dans le monde, y compris des centres spécialisés en microbiologie cosmétique.
Solutions sur mesure
Que vous lanciez une nouvelle formulation ou gériez la surveillance post-commercialisation, nous nous adaptons à vos besoins.
Précis, rapides, fiables
Un débit élevé et une consultation approfondie placent la rapidité et la qualité au même niveau, afin que vous n'ayez jamais à choisir entre les deux.